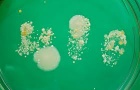

Benvenuti
Benvenuti nel sito IFNE, Istituto Formazione Nord Est in Diritto Tecnica e Controllo dei Prodotti Alimentari.
Formazione e aggiornamento come opportunità per il futuro: ecco la scelta di IFNE per creare professionalità d'avanguardia nel settore alimentare.
Rivolgendosi sia a neolauraeati e neodiplomati che ad operatori già attivi, IFNE promuove figure qualificate ed altamente specializzate.

La medicina di genere e il genere nella medicina: la situazione attuale e prospettive future
Convegno Pordenone Lunedì 16 marzo 2026

SICUREZZA ALIMENTARE e SALUTE PUBBLICA: prevenzione e controllo del latte e suoi derivati
Convegno sulla sicurezza alimentare e salute pubblica

Convegno sul Regolamento U,E. n, 774 del 2018. Verona 2018
Etichettatura degli alimenti fra sanzioni amministrative e norme penali. Relazione dr. Lazzàro

La tutela igienico-sanitaria degli alimenti destinati al consumo umano
Convegno Ifne Venerdì 19 Gennaio 2024 - Ore 18.00

"Sicurezza Alimentare e Salute Pubblica”: Obbligo di dichiarare la provenienza degli alimenti In etichetta
Convegno Ifne Venerdì 31 marzo 2023 ore 18.00 Tesero (TN)

Convegno: La nuova sanità animale
Bolzano 25 novembre 2022

Alimenta
rivista di diritto e scienze dell’agricoltura, alimentazione e ambiente

L’errore Del Medico Competente: Profili Penali e Conseguenze
Convegno IFNE venerdì 7 OTTOBRE 2022

Presentazione libri
Sabato 8 ottobre 2022 - ore 19.00 Palazzo Ragazzoni - V.le P. Zancanaro 2 Sacile

Convegno nazionale: Concessioni Balneari
Venerdì 20 maggio - ore 9.00 - Bibione

Convegno: Alimenti e Salute Pubblica
Bolzano 25 novembre 2022

Convegno: Sicurezza alimentare e salute pubblica - Il laboratorio valido aiuto a sostegno della salute
Venerdì 18 gennaio 2019 - Auditorium Luigi Canal - Tesero

La responsabilità sanitaria alla luce della Legge Gelli
Sabato 15 settembre 2018 - ore 9.00 - Sala Convegni Istituto Vendramini - Pordenone

L'Amministratore di sostegno nella relazione con i servizi socio-sanitari
Convegno sabato 14 aprile 2018 - ore 9.00 - Sala Convegni Ospedale di Sacile

SICUREZZA ALIMENTARE - GIOVEDI' 18 GENNAIO 2018 - TESERO
Serata informativa

CONVEGNO « ALIMENTI BIOLOGICI OGM E SALUTE »
Venerdì 19 gennaio 2018 ore 9.00 Sala Convegni Comune di Predazzo

Convegno Ifne
Bolzano 6 ottobre 2017

«Il nuovo pacchetto igiene nella riforma comunitaria»
Convegno Verona 13 ottobre 2017

Le etichette alimentari: tutto quello che c'è da sapere
Seminario in rete prof. Vittorio Silano

«Sicurezza alimentare e tutela dei prodotti tipici del Trentino Alto Adige»
Giovedì 19 gennaio 2017

Il nuovo sistema di sorveglianza epidemiologica per la tutela della sanità animale e della sicurezza degli alimenti
Predazzo 20 gennaio 2017

Relazioni presentate al Convegno Ifne di Bolzano
Venerdì 14 ottobre 2016

Convegno Ifne
Bolzano Venerdì 14 ottobre 2016

L’ ISTITUTO DI FORMAZIONE DEL NORD-EST HA UN NUOVO PRESIDENTE
Due Presidenti di Tribunale entrano nel Consiglio di Amministrazione dell‘IFNE

Convegno Ifne Predazzo 15 gennaio 2016
Predazzo venerdì 15 gennaio 2016

Convegno: MARTEDI’ 1° DICEMBRE 2015 - ORE 15 LONGARONE
IL GELATO ARTIGIANALE E LE NUOVE INDICAZIONI AL CONSUMATORE IN MERITO AL REG. 1169/11

Convegno Bolzano 16 ottobre 2015

Convegno Verona 25 settembre 2015

Convegno - Eurocarne Veronafiere 12 maggio 2015

Convegno - Napoli 6 marzo 2015

Convegno Nazionale - Gubbio 27-28 febbraio 2015

Convegno: alimenti pericolosi per la salute e responsabilità degli operatori nella gestione aziendale dei patogeni emergenti
Predazzo - Venerdì 16 gennaio 2015 - Sala Convegni Comune di Predazzo

Qualità del cibo, l’Ifne compie 20 anni
Cerimonia in municipio per celebrare il traguardo dell’istituto di formazione del Nordest
Convegno: "Scienza e diritto in tema di sostanze microbiche: tolleranza e conseguenze nel superamento dei limiti
Venerdì 17 ottobre 2014 Bolzano

19° Corso Ifne - Verona 19 giugno 2014 - Bolzano 17 ottobre 2014 - Predazzo 16 gennaio 2015
Il programma



















